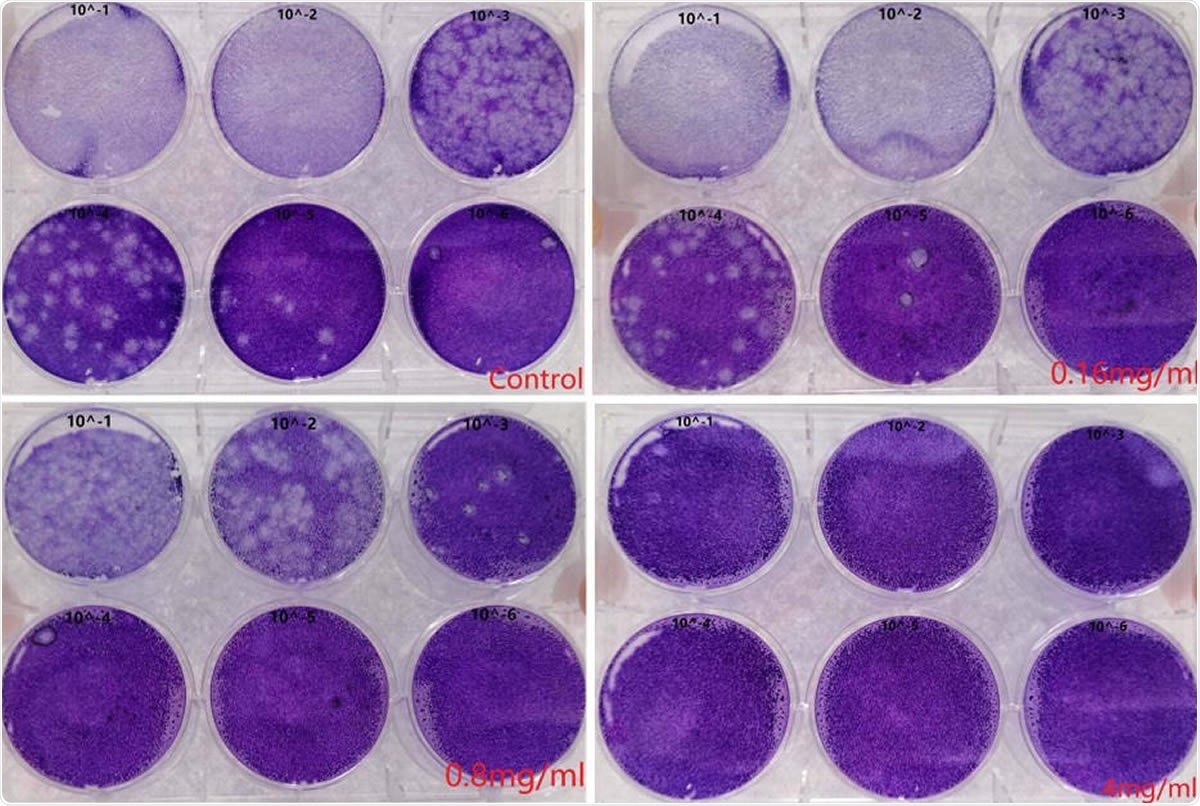
Human breastmilk inhibited infectious virus production. The virus titers of supernatant of control and different concentration of human breastmilk treatment were determined by plaque assay. MOI, multiplicity of infection; RT-qPCR, Real time quantitative polymerase chain reaction. Values are shown as mean of triplicates ± SD, **p<0.01, ***p<0.001 by unpaired two-tailed t test.

Many scientists have reported the effects of severe acute respiratory syndrome coronavirus 2 (SARS-CoV-2) infection on pregnancy and the virus has been detected in breastmilk. Now a new study published on the preprint server bioRxiv* in August 2020 shows that whey protein in human breastmilk efficiently prevents infection with SARS-CoV-2 as well as post-entry viral replication.
Milk contains an abundance of useful components such as proteins, minerals, vitamins, and antimicrobial compounds. It antagonizes the activity of viruses like hepatitis C virus (HCV), human cytomegalovirus (HCMV) and human immunodeficiency virus (HIV). Milk lactoferrin inhibits the intracellular replication of HCV.
The current study aimed to examine the activity of whey protein in human breastmilk against SARS-CoV-2 and the pangolin coronavirus GX_P2V, which is closely related to it.
Inhibition of SARS-CoV-2 Pseudovirus By Human Breastmilk
The researchers found that Vero cells infected with pseudovirus expressing SARS-CoV-2 antigens in the presence of breastmilk, all the milk samples from different donors efficiently inhibited over 98% of infection, in both the original condition and at serial two-fold dilutions. Different samples showed different EC50, the 50% of maximal effect, from 0.02 mg/mL to 0.25 mg/mL.At the same time, the half-maximal cytotoxicity concentration CC50 was over 3 mg/mL, showing the high safety profile.
Human breastmilk inhibited infectious virus production. The virus titers of supernatant of control and different concentration of human breastmilk treatment were determined by plaque assay. MOI, multiplicity of infection; RT-qPCR, Real time quantitative polymerase chain reaction. Values are shown as mean of triplicates ± SD, **p<0.01, ***p<0.001 by unpaired two-tailed t test.

 This news article was a review of a preliminary scientific report that had not undergone peer-review at the time of publication. Since its initial publication, the scientific report has now been peer reviewed and accepted for publication in a Scientific Journal. Links to the preliminary and peer-reviewed reports are available in the Sources section at the bottom of this article. View Sources
This news article was a review of a preliminary scientific report that had not undergone peer-review at the time of publication. Since its initial publication, the scientific report has now been peer reviewed and accepted for publication in a Scientific Journal. Links to the preliminary and peer-reviewed reports are available in the Sources section at the bottom of this article. View Sources
Inhibition of GX_P2V By Human Breastmilk
When repeated with the pangolin CoV, inhibition occurred to almost 100%, and dose-dependent inhibition was observed following two-fold serial dilutions. The EC50 ranged between donors, from 0.34 mg/mL to 0.79 mg/mL, while the milk promoted cell proliferation.
Inhibition of Infectious Virus Production by Human Breastmilk
The researchers also found that at varying concentrations from 0.16 mg/mL to 4 mg/mL, human breastmilk showed a dose-dependent inhibition of viral infection. When the supernatant was used to infect other cells, plaque assays showed that all control dishes were positive for the live virus, and the titer went down with dilution of supernatant. However, when treated with 4 mg breastmilk, no live virus was found in any dish. At 0.16 mg/mL, live virus was detected below a supernatant dilution of 1: 1,000 and even below 1: 10,000. Thus, human breastmilk inhibits infectious particle production.
Different Whey Proteins Inhibit SARS-CoV-2
The researchers also showed that whey protein in cow and goat milk also inhibits the virus in Vero cells, even when obtained from commercial cow’s milk. These results were obtained in pseudoviruses as well. However, human skimmed breastmilk was markedly more effective than cow or goat whey protein.
The whey protein in breastmilk was inactivated by heating to 90 °C for 10 minutes, as well as by treating with protease K. This showed that whey protein itself was the antiviral factor in the milk.
Lactoferrin and IgA Effects on SARS-CoV-2 virus
The investigators found that the virus was inefficiently inhibited by lactoferrin from human milk, goat milk, and recombinant lactoferrin compared to human breastmilk. These results were repeated with the pangolin CoV. Thus lactoferrin does not appear to be responsible for the antiviral effects of human breastmilk.
IgA antibody from recovered COVID-19 patients was mixed with the human breastmilk. This was because the breastmilk samples were obtained in 2017, before the onset of the pandemic. At all dilutions, the IgA failed to produce any alteration in the rate of infection, proving that its presence is not responsible for the efficient inhibitory activity of human breastmilk.
Whey Inhibits Viral Attachment, Entry and Post-Entry Replication
The study also shows that the presence of whey protein inhibits viral attachment as well as the entry process. The researchers also observed that after viral entry, treatment with human breastmilk inhibited replication at high efficiency for both viruses.
Implications
The current study used SARS-CoV-2 pseudoviruses for reasons of biosafety, in addition to the pangolin CoV. These are considered to be good alternative models to study various characteristics of the wildtype virus without the requirement for biosafety level 2 facilities. The observation that human breastmilk has potent antiviral activity against these two different but closely related coronaviruses in two different cell lines indicates that it could prevent infection by and replication of SARS-CoV-2.
It is also clear that the same inhibitory capacity is present in whey protein from other species though at lower efficiency. Antiviral factors seem to be more abundant in human breastmilk compared to that of other species. Lactoferrin and IgA do not appear to account for the antiviral activity, especially since lactoferrin is much lower in non-human milk.
The researchers suggest that more study is required to elucidate the mechanism of anti-SARS-CoV-2 activity of whey protein of human breastmilk. This could help develop effective antiviral drugs to help treat COVID-19.

 This news article was a review of a preliminary scientific report that had not undergone peer-review at the time of publication. Since its initial publication, the scientific report has now been peer reviewed and accepted for publication in a Scientific Journal. Links to the preliminary and peer-reviewed reports are available in the Sources section at the bottom of this article. View Sources
This news article was a review of a preliminary scientific report that had not undergone peer-review at the time of publication. Since its initial publication, the scientific report has now been peer reviewed and accepted for publication in a Scientific Journal. Links to the preliminary and peer-reviewed reports are available in the Sources section at the bottom of this article. View Sources